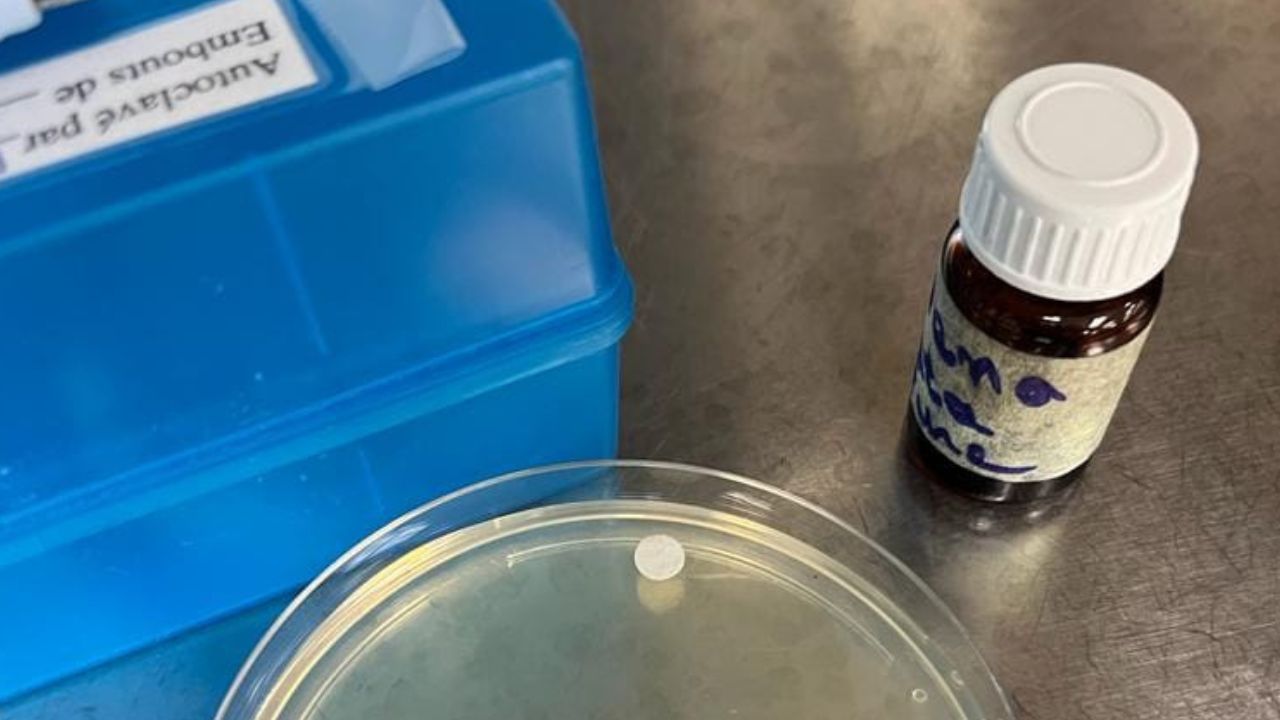
Huile essentielle clausena anisata

Bénin/Abomey-Calavi : le domicile du professeur Thiery Alavo cambriolé, sacs de riz, tablettes et autres biens emportés
Le professeur Thiery Alavo, enseignant-chercheur à l’Université d’Abomey-Calavi, a été victime d’un cambriolage aussi surprenant qu’audacieux dans sa résidence située à Tokan, commune d’Abomey-Calavi. Les cambrioleurs se sont introduits dans…